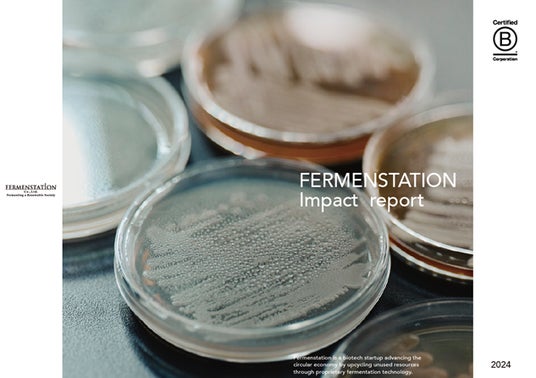

独自の発酵技術で未利用資源を再生・循環させる社会を構築する研究開発型スタートアップの株式会社ファーメンステーション(本社:東京都、代表取締役:酒井 里奈)は、2024年度のインパクトレポートを公開しました。当社は創業以来、事業性と社会性の両立を目指し、その両面でポジティブなインパクトの創出を追求してまいりました。2024年度版では独自のインパクトモデルを再構築。その背景やプロセスを経営陣の座談会形式で公開するとともに、一年を通して事業活動から生まれたソーシャルインパクトを振り返りました。
■「インパクトレポート2024」公開にあたり
ファーメンステーションは、創業以来、事業性と社会性両面でのインパクトを会社や事業の規模に関係なく常に両立させ、拡大し続けることを追求しています。その中で、改めてファーメンステーションらしいインパクト創出のゴールやモデルを言語化するとともに、自分たちの活動を多面的に振り返り、成果を検証する必要性を感じていました。
このような背景から、2024年はインパクトモデルの再構築に着手。3回目の発行となる本レポートでは、1年をかけて構築したインパクトモデルを公開、モデル構築に関する経営メンバーの座談会を収録しています。
また、食品・飲料領域に算入するなど、事業活動においても節目の年となった2024年の事業活動を振り返り、事業活動から生まれる社会的インパクトを定性・定量的に可視化。
今後のインパクトマネジメント体制の構築と、さらなるインパクト創出を目指します。
■「インパクトレポート2024」の概要
主な章立ては下記の通りです。
1. はじめに
2. パーパス
3. 特別対談 馬田隆明氏(東京大学 FoundX ディレクター及び公益財団法人 国際文化会館 上席客員研究員 PEP ディレクター)×酒井里奈
4. ファーメンステーションについて
創業ストーリー/取り組む社会課題/課題解決アプローチ/事業について/技術について/外部認証/組織・バリュー/ステークホルダーetc…
5. インパクトモデル
インパクトモデル/インパクトモデル座談会
6. インパクトの取り組みと今後
2024年のハイライト/数字で見るファーメンステーション/年間トピックス/節目となった2024年/今後に向けて

(レポート誌面より抜粋)
▼「インパクトレポート2024」は、下記URLよりご覧ください。
https://fermenstation.co.jp/report/
<株式会社ファーメンステーションについて>
ファーメンステーションは「Fermenting a Renewable Society(発酵で楽しい社会を!)」をパーパスに、未利用資源を再生・循環させる社会の構築を目指すバイオものづくりスタートアップです。独自の未利用バイオマス・微生物データベースと発酵アップサイクル技術を活用し、フードロス/ウェイストおよびその他未利用バイオマス由来のバイオ素材を開発・製造しています。発酵アップサイクル技術の基盤と、開発するアップサイクル原料をもとに、化粧品等の原料製造・販売を行う「原料事業」、パートナー企業と共創し食品・飲料工場の製造過程等で出る副産物・食品残さ等をアップサイクルしたバイオ素材等を開発する「共創事業」等を展開しています。
岩手県奥州市に自社工場を持つことで、開発から製造まで一気通貫で対応可能であり、製造過程で生じる発酵副産物を化粧品原料や地域の鶏や牛の飼料として最大限利用することで、可能な限り廃棄物を少なくする循環型モデルを構築し、地域循環型社会の形成にも取り組んでおります。
また、地域社会、環境、カスタマー、従業員に対して多面的・包括的な利益を生む事業活動を実践する企業を認証する国際的な制度「B Corp 認証」を取得しており、経済産業省から「J-Startup」「J-Startup Impact」に選定されています。
会社名 : 株式会社ファーメンステーション / Fermenstation Co.,Ltd.
代表者 : 代表取締役 酒井 里奈
所在地 : 〒130-0005 東京都墨田区東駒形2丁目20-2
事業内容 : 発酵アップサイクル技術を活用した未利用バイオマス(フードロス等)由来のバイオ素材の研究開発および製造販売、独自技術・ノウハウを活用した事業共創・共同研究開発、アップサイクル原料を活用した化粧品・雑貨OEM/ODM
コーポレートサイト :https://fermenstation.co.jp/
事業共創 :https://fermenstation.co.jp/collabo/
技術 :https://fermenstation.co.jp/technology/
このニュースに関するお問い合わせは、下記までお願いいたします。
株式会社ファーメンステーション 渡辺 麻貴
Tel:03-6206-9485 E-mail:info@fermenstation.jp